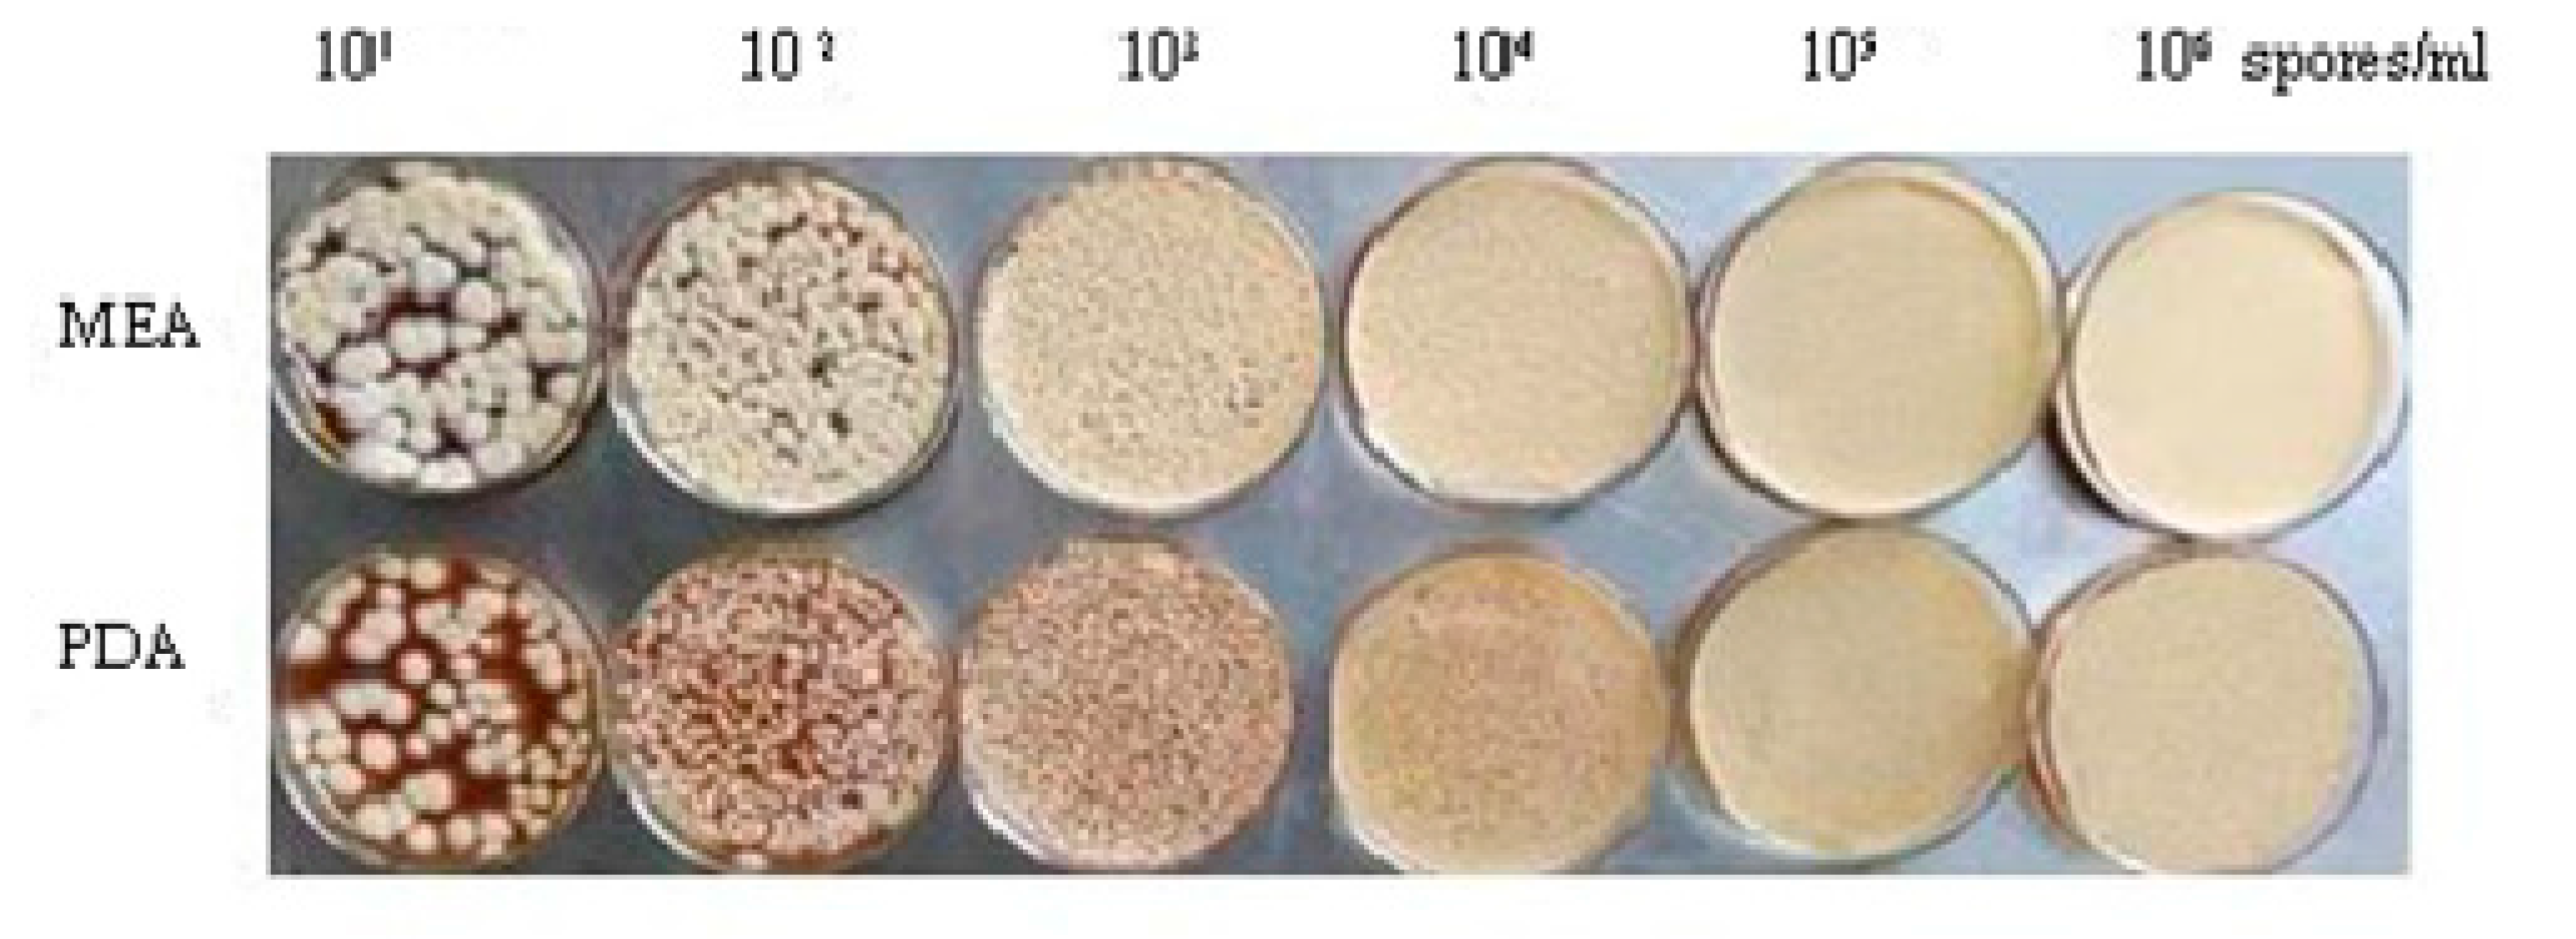
Toxins 09 00146 g006 550

Initial Spore Density Has an Influence on Ochratoxin A Content in Aspergillus ochraceus CGMCC 3.4412 in PDB and Its Interaction with Seeds
Abstract
:1. Introduction
2. Results
2.1. Spore Density-Dependent OTA Production in Potato Dextrose Broth (PDB) Media
2.2. Influence of Spore Densities on Transcript Levels of OTA Biosynthesis-Related Genes
2.3. Oxylipin-Mediated Host-Fungus Cross Talk
2.4. Effects of A. ochraceus Infection on MDA
2.5. Effects of A. ochraceus Infection on ROS Activity and Antioxidant Enzymes
3. Discussion
4. Conclusions
5. Materials and Methods
5.1. Fungal Strain and Culture Conditions
5.2. Determinations of Fungal Dry Weights and OTA Content
5.3. Extraction of RNA and Preparation of cDNA
5.4. qRT-PCR Analysis of Gene Transcript Accumulation
5.5. Peanut, Bean, Wheat and Maize Seed Infection Studies and OTA Analysis from Seeds
5.6. Measurement of ROS, MDA, and Antioxidant Enzymes
Acknowledgments
Author Contributions
Conflicts of Interest
Abbreviations
| ISD | Initial spore density |
| FA | Fatty acids |
| AF | Aflatoxin |
| QS | Quorum sensing |
| OTA | Ochratoxin A |
| CGMCC | China General Microbiological Culture |
| IARC | International Agency for Research on Cancer Collection Center |
| ROS | Reactive oxygen species |
| SOD | Superoxide Dismutase |
| CAT | Catalase |
| MDA | Malonic dialdehyde |
| POD | Peroxidase |
References
- Bui-Klimke, T.R.; Wu, F. Ochratoxin A and human health risk: A review of the evidence. Crit. Rev. Food Sci. Nutr. 2015, 55, 1860–1869. [Google Scholar] [CrossRef] [PubMed]
- Evaluation of certain mycotoxins in food. In Fifty-Sixth Report of the Joint FAO/WHO Expert Committee on Food Additives; World Health Organization: Geneva, Switzerland, 2002; Volume 906, i–viii; pp. 1–62.
- Duarte, S.C.; Pena, A.; Lino, C.M. Human ochratoxin A biomarkers-From exposure to effect. Crit. Rev. Toxicol. 2011, 41, 187–212. [Google Scholar] [CrossRef] [PubMed]
- Boeniger, M.; Combes, R.D.; Dragani, T.A.; Fitzgerald, J.; Hardin, B.D.; Hayes, R.B.; Kadlubar, F.; Kinlen, L.J.; Kriek, E.; Lynge, E. Iarc Monographs Program on the Evaluation Of Carcinogenic Risks To Humans. IARC Monog. Eval. Carcinog. 1993, 7, 13–33. [Google Scholar]
- Fazekas, B.; Tar, A.; Kovacs, M. Ochratoxin a content of urine samples of healthy humans in Hungary. Acta Vet. Hung. 2005, 53, 35–44. [Google Scholar] [CrossRef] [PubMed]
- Petzinger, E.; Ziegler, K. Ochratoxin A from a toxicological perspective. J. Vet. Pharmacol. Ther. 2000, 23, 91–98. [Google Scholar] [CrossRef] [PubMed]
- Pardo, E.; Marin, S.; Ramos, A.; Sanchis, V. Occurrence of ochratoxigenic fungi and ochratoxin A in green coffee from different origins. Food Sci. Technol. Int. 2004, 10, 45–49. [Google Scholar] [CrossRef]
- Pitt, J.I. Toxigenic fungi: Which are important? Med. Mycol. 2000, 38, 17–22. [Google Scholar] [CrossRef] [PubMed]
- Bau, M.; Bragulat, M.R.; Abarca, M.L.; Minguez, S.; Cabañes, F.J. Ochratoxigenic species from Spanish wine grapes. Int. J. Food Microbiol. 2005, 98, 125–130. [Google Scholar] [CrossRef] [PubMed]
- Bayman, P.; Baker, J.L.; Doster, M.A.; Michailides, T.J.; Mahoney, N.E. Ochratoxin production by the Aspergillus ochraceus group and Aspergillus alliaceus. Appl. Environ. Microbiol. 2002, 68, 2326–2329. [Google Scholar] [CrossRef] [PubMed]
- O’Callaghan, J.; Stapleton, P.C.; Dobson, A.D. Ochratoxin A biosynthetic genes in Aspergillus ochraceus are differentially regulated by pH and nutritional stimuli. Fung. Genet. Biol. 2006, 43, 213–221. [Google Scholar] [CrossRef] [PubMed]
- Varga, J.; Rigo, K.; Teren, J.; Mesterhazy, A. Recent advances in ochratoxin research - II. Biosynthesis, mode of action and control of ochratoxins. Cereal Res. Commun. 2001, 29, 93–100. [Google Scholar]
- Harris, J.P.; Mantle, P.G. Biosynthesis of ochratoxins by Aspergillus ochraceus. Phytochemistry 2001, 58, 709–716. [Google Scholar] [CrossRef]
- Lee, S.E.; Park, B.S.; Bayman, P.; Baker, J.L.; Choi, W.S.; Campbell, B.C. Suppression of ochratoxin biosynthesis by naturally occurring alkaloids. Food Addit. Contam. 2007, 24, 391–397. [Google Scholar] [CrossRef] [PubMed]
- Reverberi, M.; Punelli, F.; Scarpari, M.; Camera, E.; Zjalic, S.; Ricelli, A.; Fanelli, C.; Fabbri, A.A. Lipoperoxidation affects ochratoxin A biosynthesis in Aspergillus ochraceus and its interaction with wheat seeds. Appl. Microbiol. Biotechnol. 2010, 85, 1935–1946. [Google Scholar] [CrossRef] [PubMed]
- Albuquerque, P.; Casadevall, A. Quorum sensing in fungi—A review. Med. Mycol. 2012, 50, 337–345. [Google Scholar] [CrossRef] [PubMed]
- Brown, S.H.; Scott, J.B.; Bhaheetharan, J.; Sharpee, W.C.; Milde, L.; Wilde, L.; Wilson, R.A.; Keller, N.P. Oxygenase coordination is required for morphological transition and the host-fungus interaction of Aspergillus flavus. Mol. Plant-Microbe Interact. 2009, 22, 882–894. [Google Scholar] [CrossRef] [PubMed]
- Raina, S.; Vizio, D.D.; Keshavarz, T. Quorum sensing in filamentous fungi. J. Biotechnol. 2010, 150, 76. [Google Scholar] [CrossRef]
- Brown, S.H.; Zarnowski, R.; Sharpee, W.C.; Keller, N.P. Morphological transitions governed by density dependence and lipoxygenase activity in Aspergillus flavus. Appl. Environ. Microbiol. 2008, 74, 5674–5685. [Google Scholar] [CrossRef] [PubMed]
- Affeldt, K.J.; Brodhagen, M.; Keller, N.P. Aspergillus oxylipin signaling and quorum sensing pathways depend on g protein-coupled receptors. Toxins 2012, 4, 695–717. [Google Scholar] [CrossRef] [PubMed]
- Singh, A.; Del Poeta, M. Lipid signalling in pathogenic fungi. Cell Microbiol. 2011, 13, 177–185. [Google Scholar] [CrossRef] [PubMed]
- Reverberi, M.; Zjalic, S.; Ricelli, A.; Punelli, F.; Camera, E.; Fabbri, C.; Picardo, M.; Fanelli, C.; Fabbri, A.A. Modulation of antioxidant defense in Aspergillus parasiticus is involved in aflatoxin biosynthesis: A role for the ApyapA gene. Eukaryot. Cell 2008, 7, 988–1000. [Google Scholar] [CrossRef] [PubMed]
- Mecocci, P.; Polidori, M.C. Oxidative stress in human aging and in age-related diseases. Free Radic. Res. 2002, 36, 21–23. [Google Scholar]
- Calvo, A.M.; Gardner, H.W.; Keller, N.P. Genetic connection between fatty acid metabolism and sporulation in Aspergillus nidulans. J. Biol. Chem. 2001, 276, 25766–25774. [Google Scholar] [CrossRef] [PubMed]
- Severns, D.E.; Clements, M.J.; Lambert, R.J.; White, D.G. Comparison of Aspergillus ear rot and aflatoxin contamination in grain of high-oil and normal-oil corn hybrids. J. Food Prot. 2003, 66, 637–643. [Google Scholar] [CrossRef] [PubMed]
- Yan, S.J.; Liang, Y.T.; Zhang, J.D. Autoxidated linolenic acid inhibits aflatoxin biosynthesis in Aspergillus flavus via oxylipin species. Fung. Genet. Biol. 2015, 81, 229–237. [Google Scholar] [CrossRef] [PubMed]
- Lambeth, J.D. NOX enzymes and the biology of reactive oxygen. Nat. Rev. Immunol. 2004, 4, 181–189. [Google Scholar] [CrossRef] [PubMed]
- Lara-Ortiz, T.; Riveros-Rosas, H.; Aguirre, J. Reactive oxywgen species generated by microbial NADPH oxidase NoxA regulate sexual development in Aspergillus nidulans. Mol. Microbiol. 2003, 50, 1241–1255. [Google Scholar] [CrossRef] [PubMed]
- Chang, P.K.; Bennett, J.W.; Cotty, P.J. Association of aflatoxin biosynthesis and sclerotial development in Aspergillus parasiticus. Mycopathologia 2002, 153, 41–48. [Google Scholar] [CrossRef] [PubMed]
- Shimizu, K.; Keller, N.P. Genetic involvement of a cAMP-dependent protein kinase in a G protein signaling pathway regulating morphological and chemical transitions in Aspergillus nidulans. Genetics 2001, 157, 591–600. [Google Scholar] [PubMed]
- Narasaiah, K.V.; Sashidhar, R.B.; Subramanyam, C. Biochemical analysis of oxidative stress in the production of aflatoxin and its precursor intermediates. Mycopathologia 2006, 162, 179–189. [Google Scholar] [CrossRef] [PubMed]
- Nanjing Jiancheng Bioengineering Institute. Available online: http://www.njjcbio.com (accessed on 18 March 2016).

| Primer | Sequence | Annealing Temperature | Reference |
|---|---|---|---|
| Pks-F | TTCTCTGCGCTTCTCACATC | 60 °C | [11] |
| Pks-R | AACATCATAAGAGGTCAACA | 60 °C | [11] |
| P450-B03-F | CTCGGTGACATCAGGGGTATC | 60 °C | [11] |
| P450-B03-R | AGCGTATTCAGTCACTCATTCAGA | 60 °C | [11] |
| P450-H11-F | AGAACGGGATGCCAAAACAGTGAG | 64 °C | [11] |
| P450-H11-R | AAGAATGCGAGGGATGGGATAACC | 64 °C | [11] |
| Ao-18s-F | ATGGCCGTTCTTAGTTGGTG | 60 °C | [15] |
| Ao-18s-R | GTACAAAGGGCAGGGACGTA | 60 °C | [15] |
© 2017 by the authors. Licensee MDPI, Basel, Switzerland. This article is an open access article distributed under the terms and conditions of the Creative Commons Attribution (CC BY) license (http://creativecommons.org/licenses/by/4.0/).
Share and Cite
Li, C.; Song, Y.; Xiong, L.; Huang, K.; Liang, Z. Initial Spore Density Has an Influence on Ochratoxin A Content in Aspergillus ochraceus CGMCC 3.4412 in PDB and Its Interaction with Seeds. Toxins 2017, 9, 146. https://doi.org/10.3390/toxins9040146
Li C, Song Y, Xiong L, Huang K, Liang Z. Initial Spore Density Has an Influence on Ochratoxin A Content in Aspergillus ochraceus CGMCC 3.4412 in PDB and Its Interaction with Seeds. Toxins. 2017; 9(4):146. https://doi.org/10.3390/toxins9040146
Chicago/Turabian StyleLi, Caiyan, Yanmin Song, Lu Xiong, Kunlun Huang, and Zhihong Liang. 2017. "Initial Spore Density Has an Influence on Ochratoxin A Content in Aspergillus ochraceus CGMCC 3.4412 in PDB and Its Interaction with Seeds" Toxins 9, no. 4: 146. https://doi.org/10.3390/toxins9040146
APA StyleLi, C., Song, Y., Xiong, L., Huang, K., & Liang, Z. (2017). Initial Spore Density Has an Influence on Ochratoxin A Content in Aspergillus ochraceus CGMCC 3.4412 in PDB and Its Interaction with Seeds. Toxins, 9(4), 146. https://doi.org/10.3390/toxins9040146
